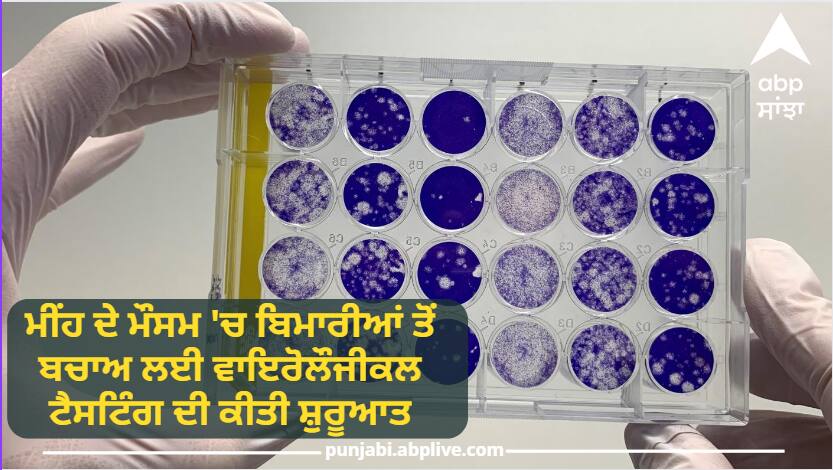

Punjab News : ਮੁੱਖ ਮੰਤਰੀ ਭਗਵੰਤ ਸਿੰਘ ਮਾਨ ਦੀ ਅਗਵਾਈ ਹੇਠਲੀ ਸਰਕਾਰ ਵੱਲੋਂ ਸੂਬਾ ਵਾਸੀਆਂ ਲਈ ਸ਼ੁੱਧ ਵਾਤਾਵਰਣ ਮਾਹੌਲ ਦੇਣ ਦੀ ਵਚਨਬੱਧਤਾ 'ਤੇ ਚੱਲਦਿਆਂ ਸਾਇੰਸ ਤਕਨਾਲੋਜੀ ਤੇ ਵਾਤਾਵਰਣ ਵਿਭਾਗ ਵੱਲੋਂ ਪੰਜਾਬ ਬਾਇਓਟੈਕਨਾਲੋਜੀ ਇਨਕਿਊਬੇਟਰ (ਪੀਬੀਟੀਆਈ) ਪਾਣੀ ਦੀ ਵਾਇਰੋਲੌਜੀਕਲ ਟੈਸਟਿੰਗ ਦੀ ਸ਼ੁਰੂਆਤ ਕੀਤੀ ਹੈ।
ਸਾਇੰਸ ਤਕਨਾਲੋਜੀ ਤੇ ਵਾਤਾਵਰਣ ਮੰਤਰੀ ਗੁਰਮੀਤ ਸਿੰਘ ਮੀਤ ਹੇਅਰ ਨੇ ਜਾਣਕਾਰੀ ਦਿੰਦਿਆਂ ਦੱਸਿਆ ਕਿ ਨੇ ਪਾਣੀ ਦੀ ਜਾਂਚ ਕਰਨ ਵਾਇਰੋਲੌਜੀਕਲ ਟੈਸਟਿੰਗ ਦੀ ਸ਼ੁਰੂਆਤ ਕੀਤੀ ਗਈ ਹੈ। ਬਾਰਸ਼ਾਂ ਦੇ ਮੌਸਮ ਵਿੱਚ ਪਾਣੀ ਤੋਂ ਹੋਣ ਵਾਲੀਆਂ ਬਿਮਾਰੀਆਂ ਜਿਵੇਂ ਕਿ ਹੈਜ਼ਾ, ਟਾਈਫਾਈਡ, ਹੈਪੇਟਾਈਟਸ (ਹੈਪੇਟਾਈਟਸ ਏ ਅਤੇ ਈ) ਅਤੇ ਦਸਤ ਆਮ ਤੌਰ 'ਤੇ ਫੈਲਦੀਆਂ ਹਨ।ਜਿਸ ਕਰਕੇ ਪਿਛਲੇ ਕੁਝ ਸਾਲਾਂ ਤੋਂ ਪੰਜਾਬ ਵਿੱਚ ਹੈਪੇਟਾਈਟਸ ਏ ਅਤੇ ਈ ਕਾਰਨ ਪਾਣੀ ਤੋਂ ਪੈਦਾ ਹੋਣ ਵਾਲੀਆਂ ਬਿਮਾਰੀਆਂ ਵਿੱਚ ਵਾਧਾ ਹੋਇਆ ਹੈ। ਹੈਪੇਟਾਈਟਸ ਏ ਪੰਜ ਸਾਲ ਤੋਂ ਘੱਟ ਉਮਰ ਦੇ ਬੱਚਿਆਂ ਅਤੇ ਹੈਪੇਟਾਈਟਸ ਈ ਗਰਭਵਤੀ ਔਰਤਾਂ ਵਿੱਚ ਪਾਇਆ ਜਾਂਦਾ ਹੈ।
ਪਾਣੀ ਦੇ ਨਮੂਨਿਆਂ ਦਾ ਵਿਸ਼ਲੇਸ਼ਣ ਕੀਤਾ ਜਾ ਰਿਹੈ - ਮੀਤ ਹੇਅਰ
ਮੀਤ ਹੇਅਰ ਨੇ ਅੱਗੇ ਦੱਸਿਆ ਕਿ ਟੈਸਟਿੰਗ ਦੀ ਸ਼ੁਰੂਆਤ ਵਿੱਚ ਐਸਏਐਸ ਨਗਰ, ਰੂਪਨਗਰ, ਲੁਧਿਆਣਾ ਅਤੇ ਮੁਕਤਸਰ ਤੋਂ ਪੀਣ ਵਾਲੇ ਪਾਣੀ ਦੇ 200 ਨਮੂਨਿਆਂ 'ਤੇ ਕੀਤੇ ਗਏ ਅਧਿਐਨ ਵਿੱਚੋਂ 10 ਫੀਸਦੀ ਵਿੱਚ ਐਮਐਸ-2 ਫੇਜ਼ਜ ਦੀ ਮੌਜੂਦਗੀ ਪਾਈ ਗਈ ਹੈ। ਮੌਜੂਦਾ ਸਮੇਂ ਵਿੱਚ ਵੱਖ-ਵੱਖ ਵਿਸ਼ਾਣੂਆਂ ਲਈ ਪਾਣੀ ਦੇ ਨਮੂਨਿਆਂ ਦਾ ਵਿਸ਼ਲੇਸ਼ਣ ਕੀਤਾ ਜਾ ਰਿਹਾ ਹੈ। ਹੈਪੇਟਾਈਟਸ ਨੂੰ ਧਿਆਨ ਵਿੱਚ ਰੱਖਦੇ ਹੋਏ ਵਾਇਰਸ ਤੋਂ ਦੂਸ਼ਿਤ ਪਾਣੀ ਦੀ ਜਾਂਚ ਵੀ ਬਹੁਤ ਮਹੱਤਵਪੂਰਨ ਹੋ ਜਾਂਦੀ ਹੈ। ਪੀਣ ਵਾਲੇ ਪਾਣੀ ਦੇ ਭਾਰਤੀ ਮਾਪਦੰਡਾਂ ਅਨੁਸਾਰ ਪਾਣੀ ਵਿੱਚ ਐਮ.ਐਸ-2 ਦੀ ਮੌਜੂਦਗੀ ਨੂੰ ਵਾਇਰੋਲੌਜੀਕਲ ਕੰਟੈਮੀਨੇਸ਼ਨ ਦਾ ਸੂਚਕ ਮੰਨਿਆ ਜਾਂਦਾ ਹੈ।
ਜ਼ਿਕਰਯੋਗ ਹੈ ਕਿ ਪੀ.ਬੀ.ਟੀ.ਆਈ. ਇੱਕ ਬਹੁ-ਖੇਤਰੀ ਹਾਈ-ਐਂਡ ਐਨਾਲਿਟੀਕਲ, ਪੰਜਾਬ ਦੀ ਪਹਿਲੀ ਐਨ.ਏ.ਬੀ.ਐਲ. ਮਾਨਤਾ ਪ੍ਰਾਪਤ ਸਹੂਲਤ ਹੈ। ਜਿਸ ਨੇ ਪੀਣ ਵਾਲੇ ਪਾਣੀ ਵਿੱਚ ਵਾਇਰਸ ਸਕਰੀਨਿੰਗ ਐਮ.ਐਸ-2 ਲਈ ਸੇਵਾਵਾਂ ਦੇਣੀਆਂ ਸ਼ੁਰੂ ਕੀਤੀਆਂ ਹਨ।
ਨੋਟ: ਪੰਜਾਬੀ ਦੀਆਂ ਬ੍ਰੇਕਿੰਗ ਖ਼ਬਰਾਂ ਪੜ੍ਹਨ ਲਈ ਤੁਸੀਂ ਸਾਡੇ ਐਪ ਨੂੰ ਡਾਊਨਲੋਡ ਕਰ ਸਕਦੇ ਹੋ।ਜੇ ਤੁਸੀਂ ਵੀਡੀਓ ਵੇਖਣਾ ਚਾਹੁੰਦੇ ਹੋ ਤਾਂ ABP ਸਾਂਝਾ ਦੇ YouTube ਚੈਨਲ ਨੂੰ Subscribe ਕਰ ਲਵੋ। ABP ਸਾਂਝਾ ਸਾਰੇ ਸੋਸ਼ਲ ਮੀਡੀਆ ਪਲੇਟਫਾਰਮਾਂ ਤੇ ਉਪਲੱਬਧ ਹੈ। ਤੁਸੀਂ ਸਾਨੂੰ ਫੇਸਬੁੱਕ, ਟਵਿੱਟਰ, ਕੂ, ਸ਼ੇਅਰਚੈੱਟ ਅਤੇ ਡੇਲੀਹੰਟ 'ਤੇ ਵੀ ਫੋਲੋ ਕਰ ਸਕਦੇ ਹੋ।
ਇਹ ਵੀ ਪੜ੍ਹੋ : Refrigerator Using Mistakes: ਬਹੁਤੇ ਲੋਕ ਨਹੀਂ ਜਾਣਦੇ ਫਰਿੱਜ ਦੀ ਸਹੀ ਵਰਤੋਂ, ਅਕਸਰ ਕਰਦੇ 3 ਖਤਰਨਾਕ ਗਲਤੀਆਂ
ਇਹ ਵੀ ਪੜ੍ਹੋ : ਕੀਤੇ ਤੁਹਾਡਾ ਬੱਚਾ ਵੀ ਤਾਂ ਨਹੀਂ ਹੋ ਰਿਹਾ ਚਿੜਚਿੜਾ! ਇਸ ਵਿਟਾਮਿਨ ਦੀ ਹੋ ਸਕਦੀ ਹੈ ਕਮੀ, ਜਾਣੋ
ਇੱਥੇ ਪੜ੍ਹੋ ਪੰਜਾਬ ਅਤੇ ਦੇਸ਼ ਦੁਨਿਆ ਨਾਲ ਜੁੜੀਆਂ ਹੋਰ ਖ਼ਬਰਾਂ
ਪੰਜਾਬੀ ‘ਚ ਤਾਜ਼ਾ ਖਬਰਾਂ ਪੜ੍ਹਨ ਲਈ ABP NEWS ਦਾ ਐਪ ਡਾਊਨਲੋਡ ਕਰੋ :
Android ਫੋਨ ਲਈ ਕਲਿਕ ਕਰੋIphone ਲਈ ਕਲਿਕ ਕਰੋ